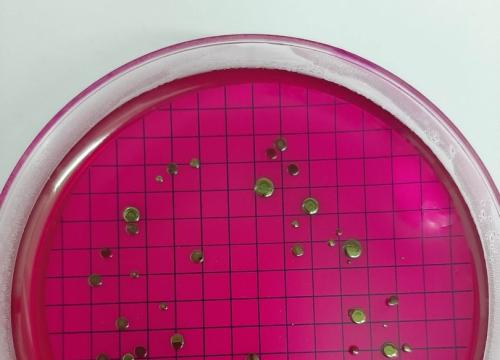
W świecie wirusów i  bakterii

W świecie wirusów i bakterii
Klasa 2aLO wzięła udział w składających się z dwóch części zajęciach warsztatowych pod hasłem „W świecie wirusów i bakterii”. W ramach zajęć w dniu 12 kwietnia uczniowie wysłuchali prelekcji „Odporność dla leniwych”, którą wygłosił lek. med. Janusz Wyrwalski. Uczestnicy dowiedzieli się jak skutecznie budować swoją odporność, czym różnią się wirusy od bakterii, czy wszystkie bakterie są groźne dla człowieka oraz jak wygląda profilaktyka chorób zakaźnych.
W drugiej części zajęć odbyły się warsztaty edukacyjne z wykorzystaniem mobilnego laboratorium. Uczniowie samodzielnie przygotowywali płyn do dezynfekcji, uczyli się poprawnie myć ręce oraz
wykonywali preparaty, które następnie oglądali pod mikroskopem.
Podsumowaniem zajęć było wykonanie graficznej notatki prezentującej omawiane wcześniej zagadnienia.
W dniu 27 kwietnia młodzież wzięła udział w lekcji pokazowej w laboratorium powiatowej Stacji Sanitarno-Epidemiologicznej Żywcu. Uczniowie zapoznali się z zakresem zadań poszczególnych sekcji takich jak na przykład: Sekcja Badań Chorób Zakaźnych i Zakażeń, Sekcja Badań Żywności, Sekcja Badań Środowiska Pracy.
Uczniowie zobaczyli jak na specjalnych pożywkach hoduje się drobnoustroje, między innymi bakterie Salmonella, Eschericha coli i Listeria monocytogenes. Uczestniczyli także w prezentacji wyposażenia pracowni mikrobiologicznej oraz pracowni badań fizyko-chemicznych żywności i wody. Młodzież dowiedziała się także, które bakterie odpowiedzialne są za dolegliwości żołądkowo-jelitowe oraz jakie są objawy zatrucia salmonellą.
Zajęcia w ciekawy i praktyczny sposób utrwaliły teoretyczną wiedzę na temat wirusów i bakterii zdobytą na lekcjach biologii.
Organizatorem zajęć była Anna Sawicka.

Biol-Chem w „Błękitnej Szkole” na Helu
23 Wrz - 12:10

10 urodziny Aqua Dance
29 Sie - 14:12

Drodzy Uczniowie!
27 Sie - 14:21

Formacja Aqua Dance na Koncercie Muzyki Filmowej
20 Sie - 22:27

Wykaz podręczników dla klasy pierwszej
07 Sie - 11:48
Powrót na start